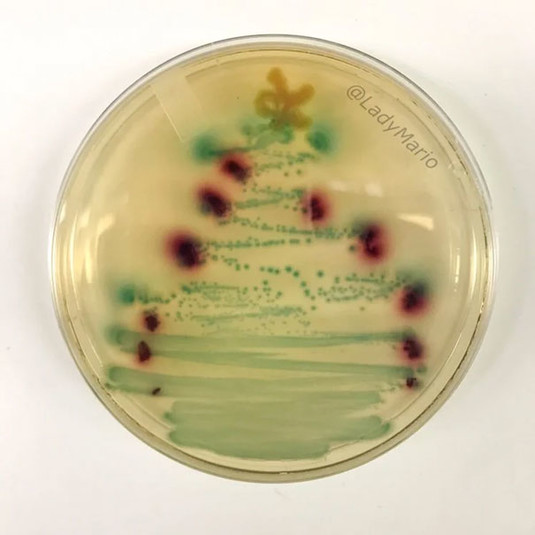

Опубликованы фото самых креативных новогодних елок

Удивите своих домочадцев и гостей — смастерите оригинальную, нетипичную новогоднюю елку своими руками из самых простых материалов
Новый год без главного атрибута - елки - не считается праздником, согласны? «Зеленая красотка» радует не только глаз, но и дарит тематический аромат, если она натуральная.
В год Свиньи эксперты рекомендуют украшать новогоднюю елку в спокойных бежевых тонах, но если душа «требует» праздника, то почему бы не нарядить дерево на свой вкус.
Кто-то использует необычные украшения или придумывает новые формы, а кто-то просто сооружает свою елку из подручных средств.
Ничего сверхъестественного не понадобится, только подручные материалы и немного фантазии. Мы вам покажем, как сделать необычную елку, смотрите фото и впитывайте идеи елок — креативных, ресурсосберегающих, экономящих пространство и защищенных от домашних любимцев.
Один из вариантов - воздушная елка из новогодних шаров. Эта елка тоже не займет много места в квартире, но ее создание потребует немного терпения. Для воплощения идеи в жизнь необходимо подвесить шары на леску разной длины и закрепить под потолком.
В качестве основания, к которому крепится воздушная елка, можно использовать ткань, туго натянутую между пяльцами, металлическую решетку для барбекю либо плоское сито без ручки.

Коментарі — 0